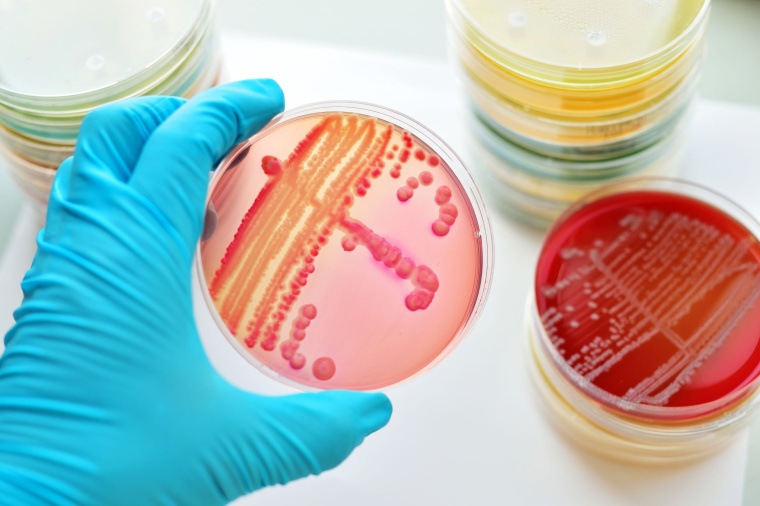
Foto: Wiley

Neue Strategien gegen die Antibiotikakrise
Kieler Forschungsteam untersucht, welche evolutionären Mechanismen sich für nachhaltige Antibiotikatherapien nutzen lassen.
Eine der gravierendsten Gefahren für die öffentliche Gesundheit weltweit geht von Antibiotika-resistenten Krankheitserregern aus. Die Weltgesundheitsorganisation WHO warnt vor dem bevorstehenden Beginn einer postantibiotischen Ära, in der eigentlich harmlose Infektionen nicht mehr behandelbar seien und erneut zu den häufigsten nicht-natürlichen Todesursachen werden könnten.
Die jahrzehntelange Nutzung verschiedener Antibiotika als Standardtherapie hat das Spektrum wirksamer antibakterieller Medikamente stark reduziert. Gleichzeitig wird die Entwicklung neuer Medikamente teilweise zurückgefahren oder ganz eingestellt. Ursache ist die schnelle Evolution von Antibiotika-Resistenzen, die antibakterielle Medikamente innerhalb kurzer Zeit wirkungslos werden lassen. Forschende verfolgen daher seit einigen Jahren das Ziel, die Wirksamkeit der noch bestehenden Wirkstoffe zu erhalten oder sogar zu verbessern.
An der Christian-Albrechts-Universität zu Kiel (CAU) forscht die Arbeitsgruppe Evolutionsökologie und Genetik intensiv an evolutionsbasierten Strategien, um durch die Kombination von Wirkstoffen bakterielle Krankheitserreger besser zu bekämpfen und gleichzeitig die Resistenzbildung zu hemmen. Ein vielversprechendes Prinzip, das die Forschenden im Rahmen des Kiel Evolution Center (KEC) nutzen wollen, ist die kollaterale Sensitivität. Dieser Fachausdruck beschreibt das Auftreten von vorteilhaften, evolutionären ‚Kosten‘ für die Entwicklung einer Antibiotikaresistenz, die immer dann entstehen, wenn die Evolution der Resistenz gegen einen Wirkstoff den Krankheitserreger gleichzeitig hochempfindlich gegen ein zweites Medikament werden lässt.
Am Beispiel des Bakteriums Pseudomonas aeruginosa haben die Forschenden dieses Prinzip nun anhand von Evolutionsexperimenten im Labor hinsichtlich seiner Stabilität und damit perspektivisch seiner nachhaltigen Nutzbarkeit im künftigen Behandlungsalltag untersucht. In einer jetzt vorgelegten Arbeit konnte das KEC-Forschungsteam zeigen, dass die wirksame Bekämpfung des Krankheitskeims bei gleichzeitiger Hemmung der Resistenzbildung vor allem von der Reihenfolge der Wirkstoffgabe und ihrer jeweiligen Wirkungsweise abhängen. Die neuen Forschungsergebnisse veröffentlichte das Kieler Team heute (29. Oktober) im Wissenschaftsjournal eLife.
Bleibt die Behandlungsempfindlichkeit der Bakterien stabil?
In einer vor zwei Jahren erschienenen Studie hatte die CAU-Arbeitsgruppe erstmals systematisch die Auswirkungen verschiedener Formen der kombinierten Antibiotika-Gabe auf die evolutionäre Anpassung von Krankheitserregern untersucht. Auch damals untersuchten die Wissenschaftler den Krankheitskeim Pseudomonas aeruginosa, der insbesondere für Patienten mit geschwächtem Immunsystem gefährlich ist. Sie konnten dabei das Prinzip der kollateralen Sensitivität erstmals auch für diesen Keim beschreiben. „Auf Basis dieser Vorarbeiten wollten wir nun herausfinden, ob sich dieses vielversprechende Prinzip auch unter wechselnden Bedingungen bestätigen lässt und ob die Sensitivität des Keimes infolge der kombinierten Medikamentengabe dauerhaft stabil bleibt“, betont CAU-Professor und KEC-Sprecher Hinrich Schulenburg.
In der nun vorgelegten Arbeit konnten die Kieler Forschenden in umfangreichen Laborexperimenten zeigen, dass es von mehreren Faktoren abhängt, ob die kollaterale Sensitivität zu therapeutischen Zwecken genutzt werden kann: Insbesondere die Abfolge und Kombination der eingesetzten Antibiotika, aber auch die evolutionären Kosten für das Bakterium und die an der Resistenzbildung beteiligten genetischen Mechanismen entscheiden über die dauerhafte Wirksamkeit. „Die Anpassungsfähigkeit des Krankheitskeims war insbesondere dann stark gehemmt, wenn der Medikamentenwechsel von einem Aminoglykosid hin zu einem Betalactam, also einem Penicillin-ähnlich Wirkstoff erfolgte,“ erläutert Dr. Camilo Barbosa, Erstautor der Studie. In diesem Fall konnten sich die Keime nicht anpassen und starben durch die kombinierte Wirkstoffgabe eher ab. Bei anderen Wirkstoffkombinationen und -wechseln gelang es den Krankheitserregern hingegen, zum Teil multiple Resistenzen auszubilden. Zusätzlich spielen die evolutionären Kosten der Resistenzevolution eine wichtige Rolle für den Therapieerfolg.
Grundlage für evolutionsbasierte Antibiotikatherapien
Die neuen Forschungsergebnisse aus dem KEC zur Wirkstoffkombination und der Stabilität der kollateralen Sensitivität könnten in Zukunft die Entwicklung neuartiger und nachhaltiger Antibiotika-Therapien erlauben. Die Effekte des Wechsels bestimmter Wirkstoffklassen und die Auswirkung der evolutionären Kosten auf die Resistenzentwicklung belegen eindrucksvoll, wie wichtig es ist, evolutionäre Prinzipien bei der Ausarbeitung neuer, nachhaltiger Therapieansätze zu berücksichtigen. „Diese aussichtsreichen evolutionsbasierten Strategien werden wir für einen möglichen Einsatz an Patientinnen und Patienten weiterentwickeln und finden hierfür im Rahmen gleich mehrerer Kieler Forschungsverbünde und in Zusammenarbeit mit den dort beteiligten Kolleginnen und Kollegen aus der Klinik fantastische Voraussetzungen“, blickt Schulenburg voraus.










